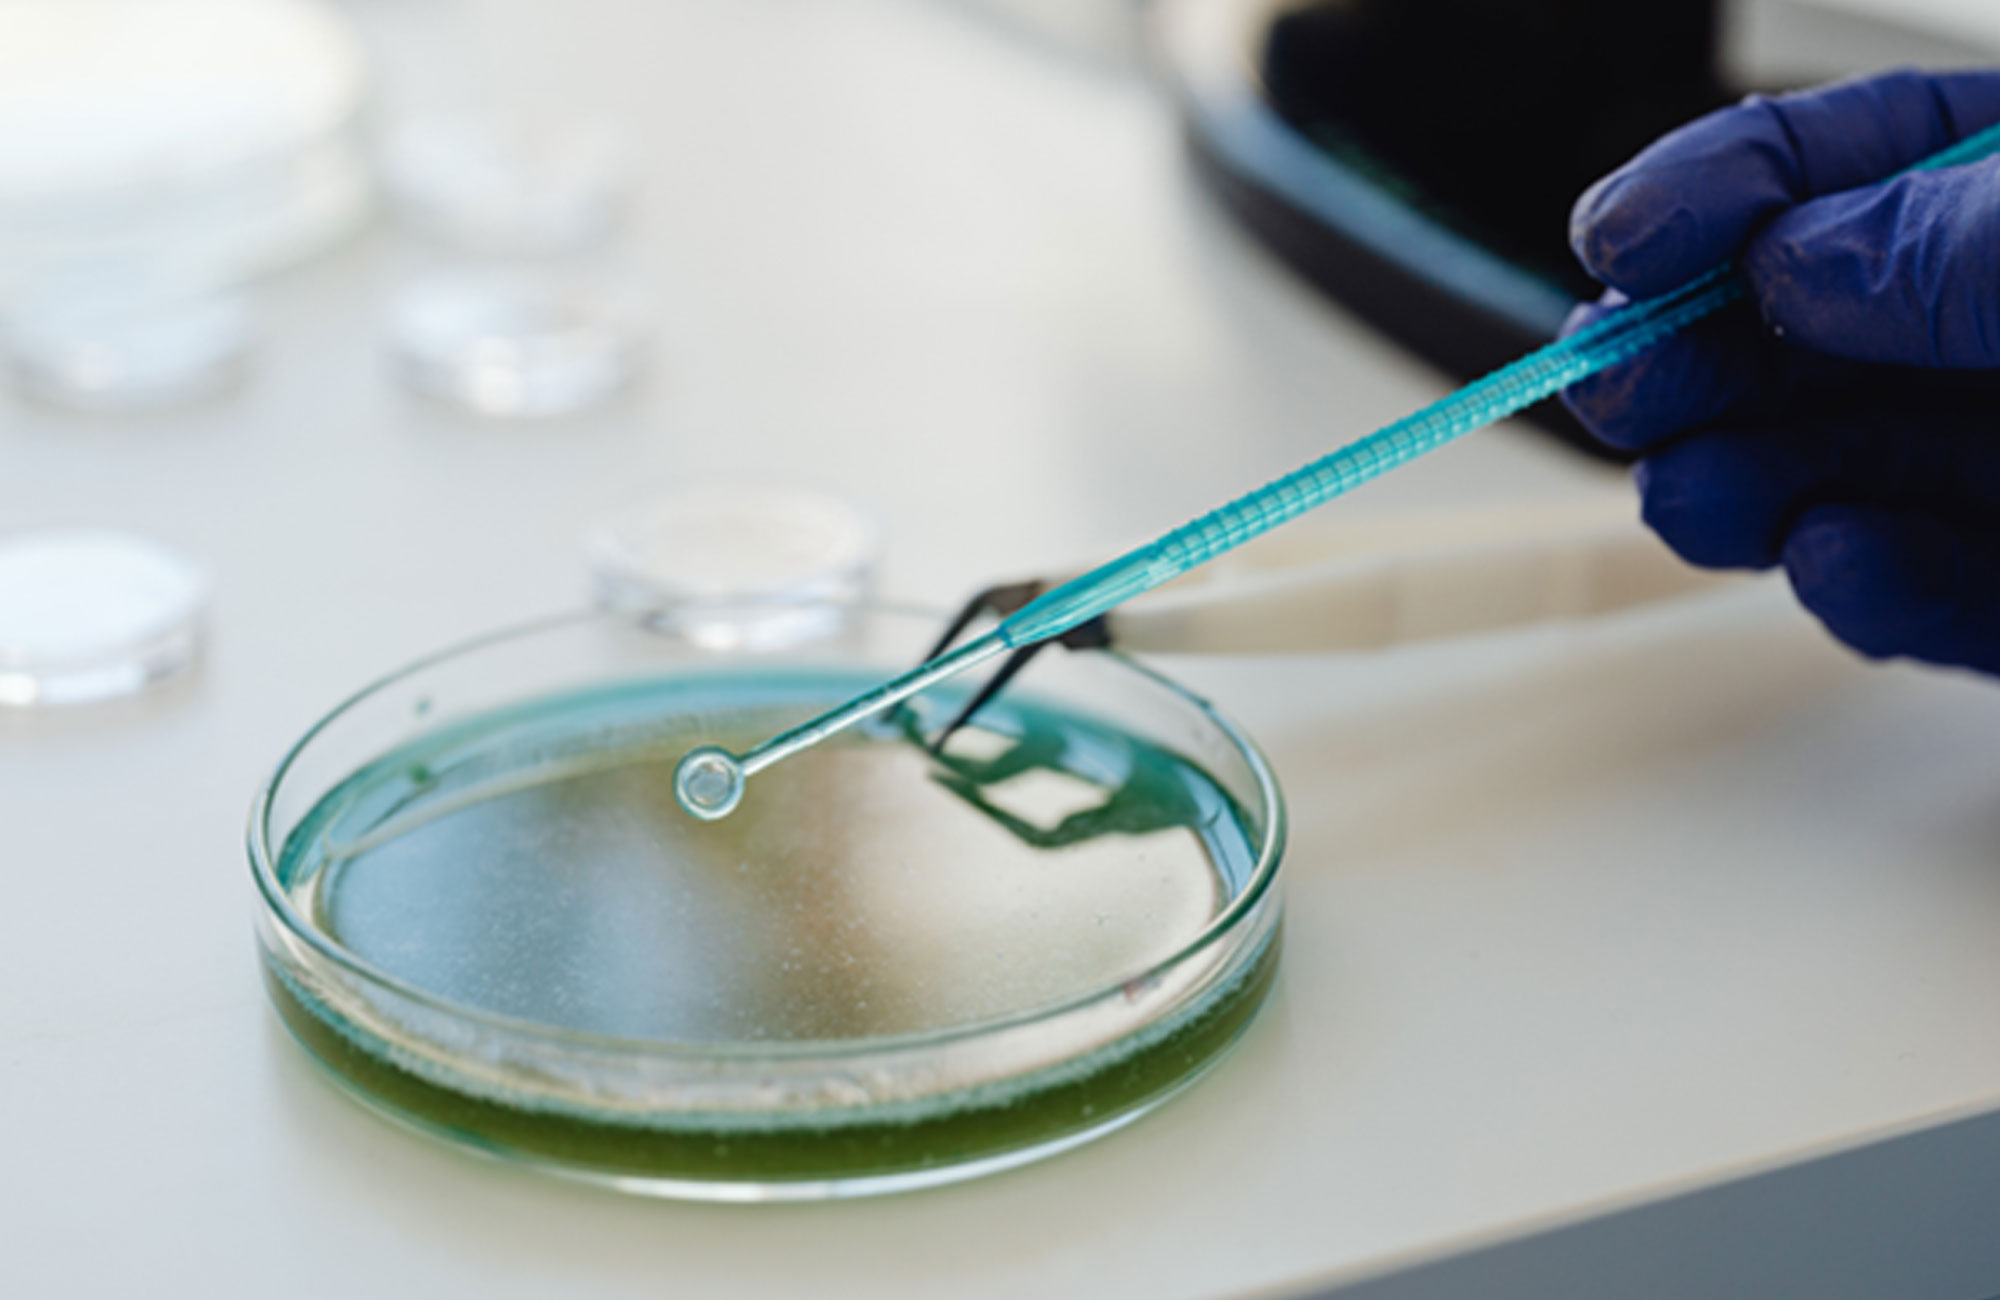
Aktiv360 | Quality, Compliance, Process Consultancy | Corporate Solutions Focused on GMP, Regulations, Validation, and Audits

Quality - compliance - process Consulting
-

Installation of Quality Management Systems
-

Production Operations, Technology Transfer & Digital Systems
-

Audit, Compliance & Risk Management
-

Validation & Verification Projects
-

Microbiology, Contamination and Enviromental Control
-

International Business Development and Contract Manufacturing Consulting